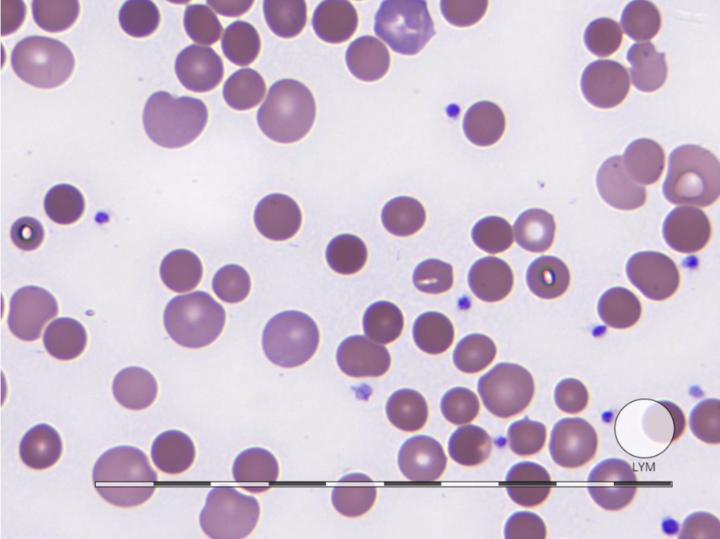
Tomás Pérez Ramirez

Activity
Mon
Wed
Fri
Sun
Jan
Feb
Mar
Apr
May
Jun
Jul
Aug
Sep
Oct
Nov
Dec
What is this?
Less
More
Memberships
Programa Qualitat-Expertise
2 members • $60/m
0 contributions to Programa Qualitat-Expertise
Tomás Pérez Ramirez hasn't contributed to Programa Qualitat-Expertise yet.
@tomas-perez-ramirez-8199
Especialista en Hematología Diagnóstica por Laboratorio, Parte del grupo de expertos del Programa Qualitat-EXpertise
Active 468d ago
Joined Sep 9, 2024
Powered by